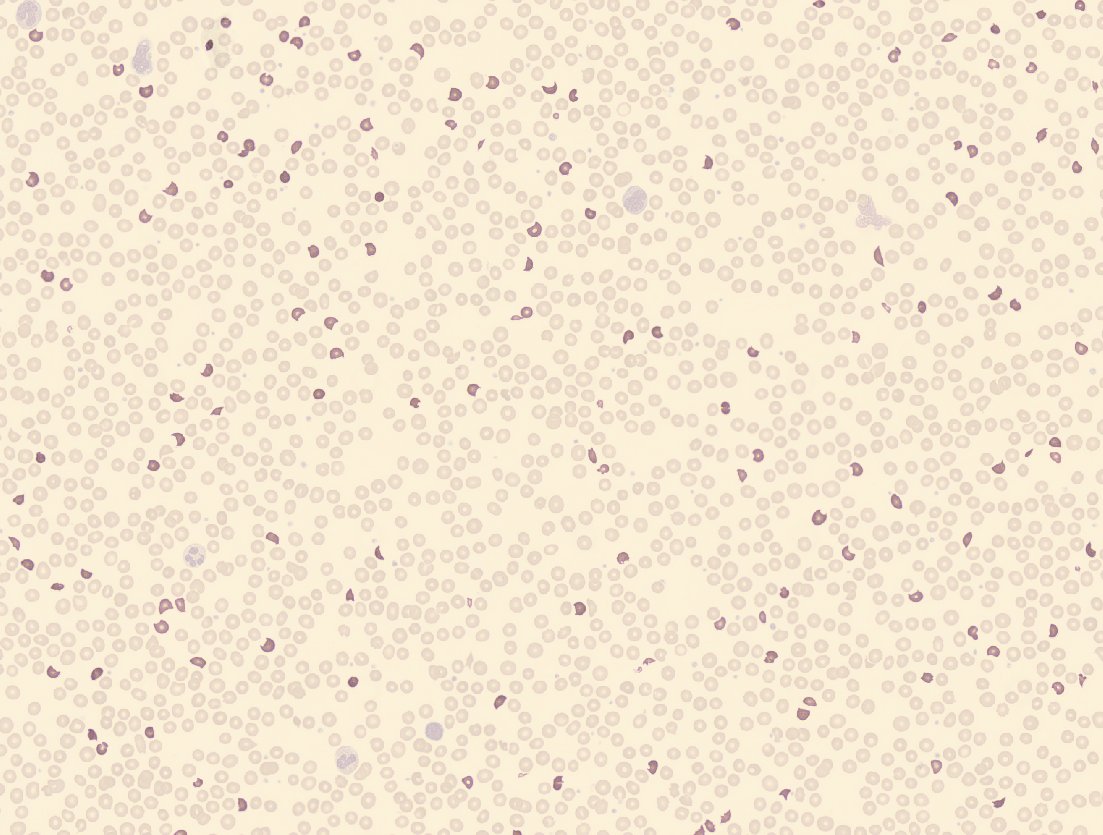
Abrumadora esquistocitosis en este paciente con síndrome hemolítico urémico mediado por E. coli, 7,4%. Imagen de CellaVision, <a href="/Sysmex_Es/">Sysmex España</a> 
#SHU
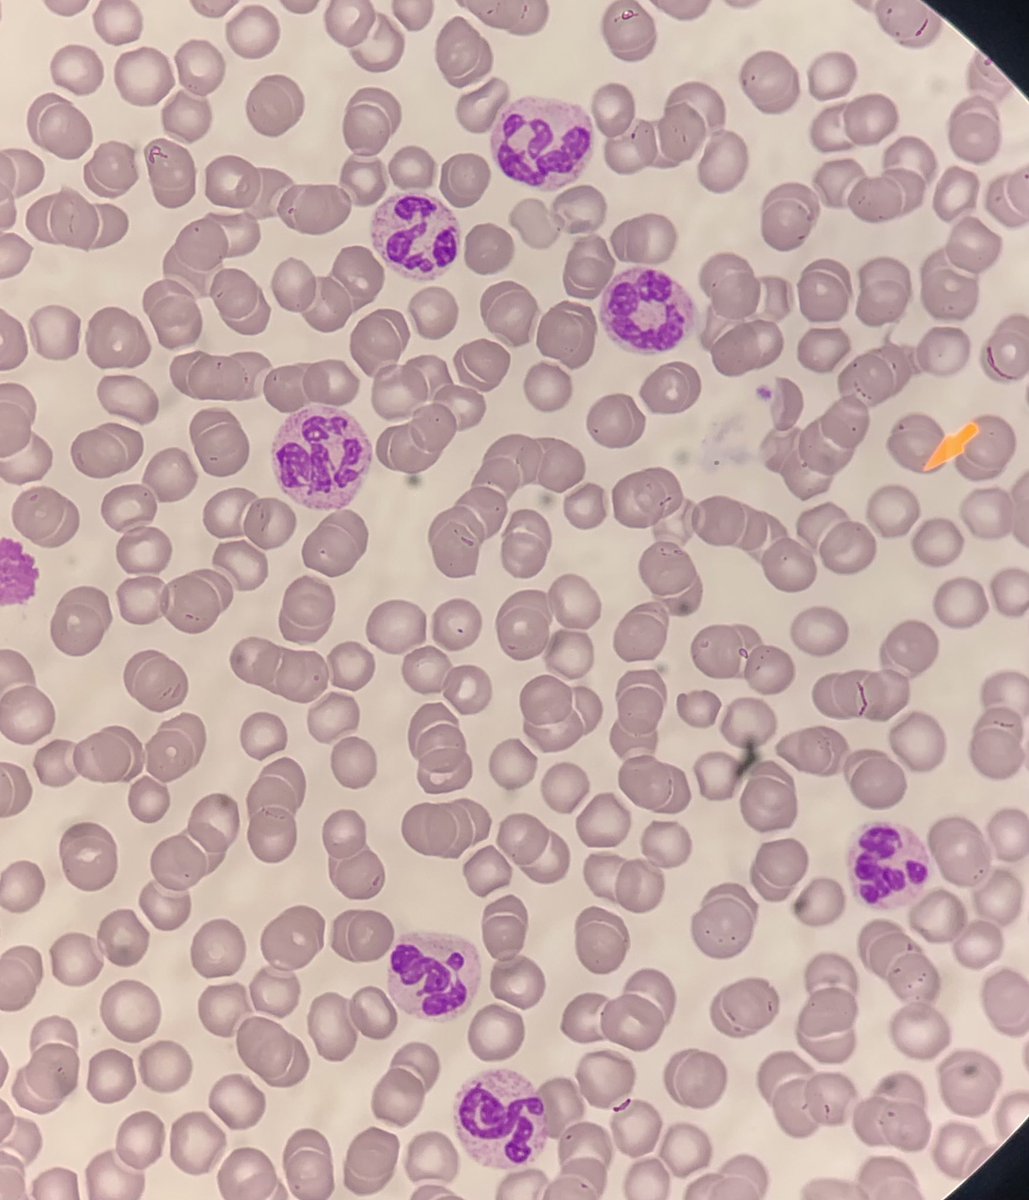
Are you aware about effects of glucocorticoids on neutrophils segmentation?hempad#

CitoTweet
@cito_tuiter
Espacio dedicado a la curiosidad hematológica. Compartir cito diagnósticos, imágenes, casos y comentarios. Citofreaks. Cytolovers. 🇪🇸.
ID: 1517988209703145474
23-04-2022 22:06:24
131 Tweet
992 Followers
358 Following

📍 Lanzamiento del proyecto ALMA sobre inteligencia artificial y medicina personalizada en enfermedades hematológicas, impulsado por el #ISCIII y @CDTI_innovacion en el marco del #PERTE_SaludDeVanguardia. 📰 Más información en #NoticiasISCIII ➡️ bit.ly/43PQtzI













🔴¡ATENCIÓN MADRILEÑOS! El día 19 de junio en el H. Severo Ochoa, de la mano de Sysmex España, hablaremos de hematimetría, de esos parámetros del hemograma que no sabes bien para qué sirven y de cómo utilizarlos en el diagnóstico de la #anemia. ¡No faltéis!


Abrumadora esquistocitosis en este paciente con síndrome hemolítico urémico mediado por E. coli, 7,4%. Imagen de CellaVision, Sysmex España #SHU